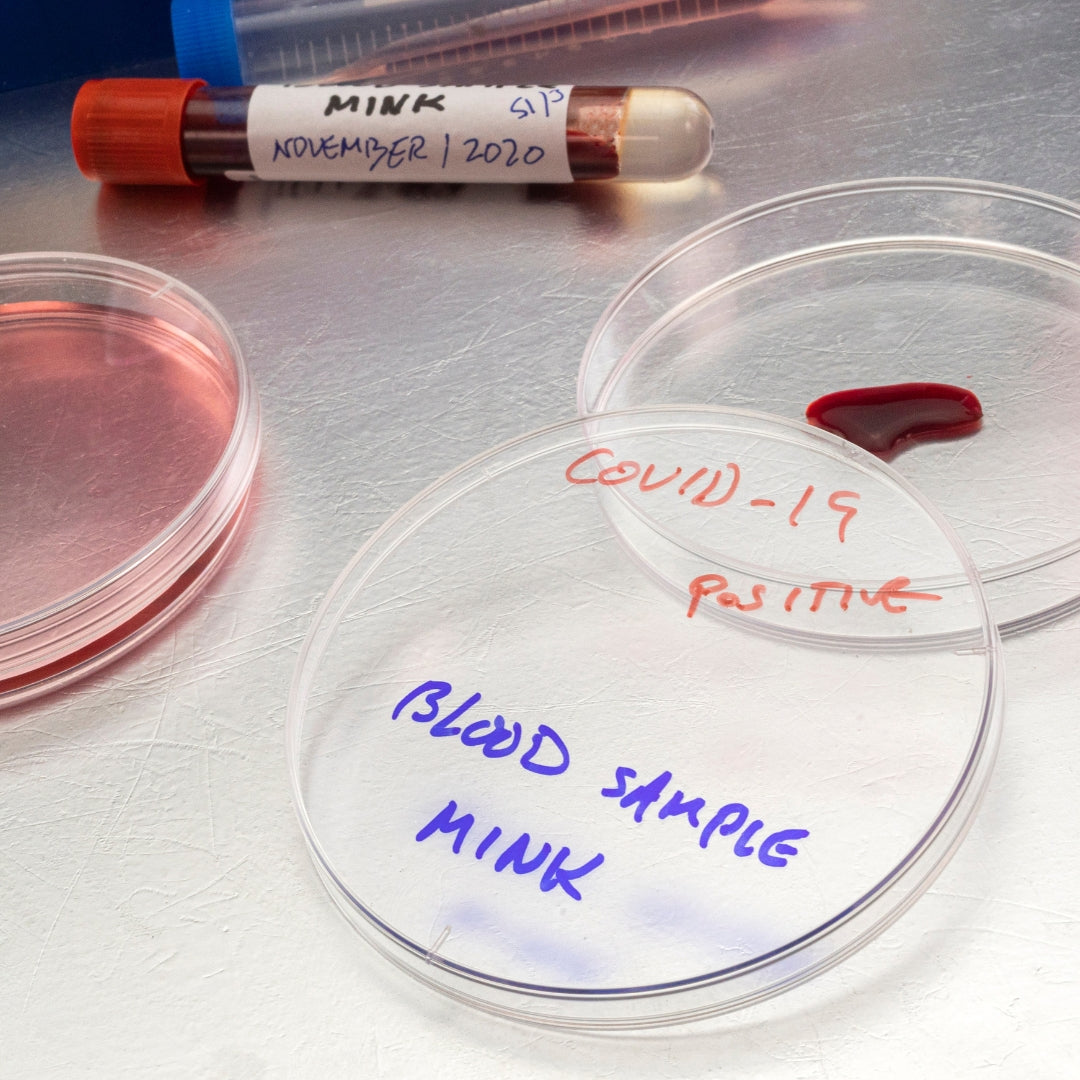
Placas Petri Plastico NO Estéril

Placas Petri Plastico NO Estéril
Placas Petri Plastico NO Estéril
Precio habitual
S/. 23.00 PEN
Precio habitual
Precio de oferta
S/. 23.00 PEN
Precio unitario
/
por
Recipiente adecuado para realizar cultivo de bacterias, hongos y células en general. Consta de dos placas una que funciona de tapa y otra de base. Diseñada para evitar la condensación al llenado y manejarse fácilmente, proveen una sujeción estable para apilarlas sin riesgo. El interior del fondo y la tapa es muy plano lo que permite la distribución uniforme de los medios de cultivo y los líquidos. Elaborada de poliestireno de alta calidad resistentes al trabajo rutinario de laboratorio. También evita la distorsión óptica. Diseñadas para cultivos e incubación de microorganismos.
|
Presentación |
Dimensiones |
|
Bolsa x 10 unidades |
90x15mm |
|
Bolsa x 10 unidades |
100x15mm |